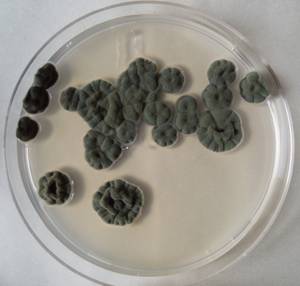
MSU_FS-03281_01, Район К Банг (K'Bang districts), Gia Lai province (Vietnam)
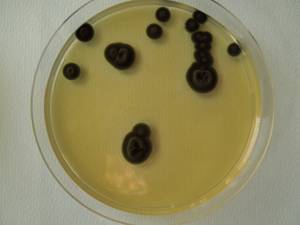
MSU_FS-02659 01, Район Кон Плонг (Kon Plông district), Kon Tum province (Vietnam)
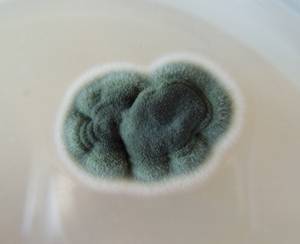
MSU_FS-02183, Район Тан Шон (Thanh Sơn district), Bến Tre Province (Vietnam)
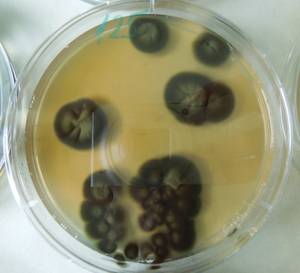
2978_MSU_FS-01, Район Манг Занг (Mang Yang districts), Gia Lai province (Vietnam)

Total items: 13
Total pages: 1
Organisms

- Specimen ID
- 0000001189964
- Species
- Cladosporium sphaerospermum
- Strain
- MSU_FS-03419
- Place of isolation
- Район Манг Занг (Mang Yang districts), Gia Lai province (Vietnam)
- Placename
- Адзун (A Yun commune)
- Specimen ID
- 0000001189754
- Species
- Cladosporium sphaerospermum
- Strain
- MSU_FS-03281
- Place of isolation
- Район К Банг (K'Bang districts), Gia Lai province (Vietnam)
- Placename
- Кронг (Kroong (K'Rong) commune)

- Specimen ID
- 0000001189752
- Species
- Cladosporium sphaerospermum
- Strain
- MSU_FS-03280
- Place of isolation
- Район К Банг (K'Bang districts), Gia Lai province (Vietnam)
- Placename
- Кронг (Kroong (K'Rong) commune)
- Specimen ID
- 0000000905762
- Species
- Cladosporium sphaerospermum
- Strain
- MSU_FS-02659
- Place of isolation
- Район Кон Плонг (Kon Plông district), Kon Tum province (Vietnam)
- Placename
- Манг Кань (Măng Cành commune)

- Specimen ID
- 0000000905636
- Species
- Cladosporium sphaerospermum
- Strain
- MSU_FS-02590
- Place of isolation
- Район Ша Тай (Sa Thầy district), Kon Tum province (Vietnam)
- Placename
- Ро Кой (Rơ Kơi commune)

- Specimen ID
- 0000000905520
- Species
- Cladosporium sphaerospermum
- Strain
- MSU_FS-02529
- Place of isolation
- Район Кон Плонг (Kon Plông district), Kon Tum province (Vietnam)
- Placename
- Манг Кань (Măng Cành commune)

- Specimen ID
- 0000000905174
- Species
- Cladosporium sphaerospermum
- Strain
- MSU_FS-02185
- Place of isolation
- Район Лак (Lắk district), Đắk Lắk province (Vietnam)
- Placename
- Бонг Кранг (Bông Krang)

- Specimen ID
- 0000000905172
- Species
- Cladosporium sphaerospermum
- Strain
- MSU_FS-02184
- Place of isolation
- Район Лак (Lắk district), Đắk Lắk province (Vietnam)
- Placename
- Бонг Кранг (Bông Krang)
- Specimen ID
- 0000000905170
- Species
- Cladosporium sphaerospermum
- Strain
- MSU_FS-02183
- Place of isolation
- Район Тан Шон (Thanh Sơn district), Bến Tre Province (Vietnam)
- Placename
- Суан Шон (Xuân Sơn commune)

- Specimen ID
- 0000000903856
- Species
- Cladosporium sphaerospermum
- Strain
- MSU_FS-00992
- Place of isolation
- Район Лак Дыонг (Lạc Dương district), Lâm Đồng province (Vietnam)
- Placename
- Да Чаис (Đạ Chais)

- Specimen ID
- 0000000903632
- Species
- Cladosporium sphaerospermum
- Strain
- MSU_FS-00869
- Place of isolation
- Район Винь Куу (Vĩnh Cửu district), Đồng Nai province (Vietnam)
- Placename
- Ма Да (Mã Đà)

- Specimen ID
- 0000000612858
- Species
- Cladosporium sphaerospermum
- Strain
- MSU_FS-02979
- Place of isolation
- Район Манг Занг (Mang Yang districts), Gia Lai province (Vietnam)
- Placename
- Адзун (A Yun commune)
- Specimen ID
- 0000000612857
- Species
- Cladosporium sphaerospermum
- Strain
- MSU_FS-02978
- Place of isolation
- Район Манг Занг (Mang Yang districts), Gia Lai province (Vietnam)
- Placename
- Адзун (A Yun commune)